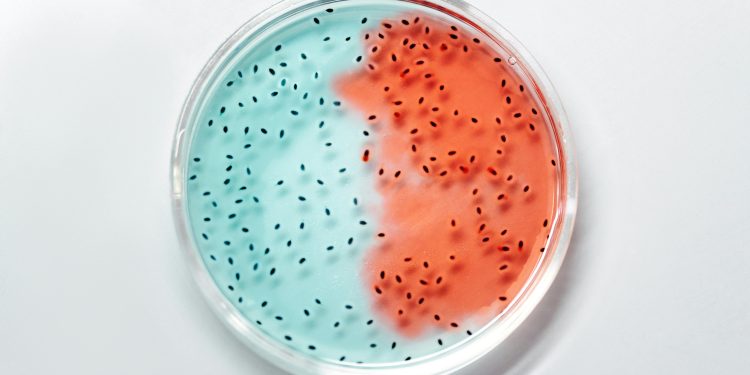

Nel corso dei primi mille giorni di vita di un bambino, che vanno dalla concezione fino ai due anni di età, si assiste a un processo straordinario di formazione e addestramento del sistema immunitario, che avviene in gran parte grazie al microbioma intestinale. Il microbioma, o flora batterica presente nel nostro intestino, svolge un ruolo fondamentale nella salute generale e nella prevenzione di malattie, e i primi anni di vita sono cruciali per la sua corretta modulazione.
Il microbioma intestinale è composto da una vasta gamma di batteri, virus, funghi e altri microorganismi che vivono all'interno del nostro intestino e svolgono numerose funzioni vitali per il nostro organismo. Questi microrganismi non sono solo ospiti passivi, ma interagiscono attivamente con il sistema immunitario, contribuendo alla sua formazione e regolazione.
Durante i primi mille giorni di vita, il microbioma del bambino subisce un processo di colonizzazione e modulazione che influenzerà la sua composizione e diversità nel corso della vita. Gli studi scientifici hanno dimostrato che un microbioma equilibrato e diversificato è fondamentale per una corretta maturazione del sistema immunitario e per la prevenzione di malattie autoimmuni, allergie e altre patologie legate all'infiammazione cronica.
Durante la gravidanza, il feto inizia a essere colonizzato dai primi microbi provenienti dalla madre, che passano attraverso la placenta e il canale del parto. Una corretta alimentazione della madre durante la gravidanza e l'allattamento al seno favoriscono il passaggio di microbioma materno al bambino, contribuendo a creare le basi per un microbioma sano e diversificato.
L'introduzione di cibi solidi nella dieta del bambino, intorno ai sei mesi di vita, è un momento cruciale per la modulazione del microbioma. La diversificazione della dieta, con l'introduzione di frutta, verdura, cereali integrali e proteine di alta qualità, favorisce la crescita di batteri benefici per la salute intestinale e generale.
L'uso di antibiotici nei primi anni di vita può alterare significativamente il microbioma, eliminando non solo i batteri dannosi ma anche quelli benefici. È importante utilizzare gli antibiotici solo quando strettamente necessario e sotto prescrizione medica, per evitare squilibri nel microbioma che potrebbero compromettere la salute del sistema immunitario.
La promozione di uno stile di vita sano, con una dieta equilibrata, l'esercizio fisico regolare e il controllo dello stress, è fondamentale per mantenere un microbioma sano e diversificato. Inoltre, l'integrazione con probiotici e prebiotici può essere utile per favorire la crescita dei batteri benefici e ristabilire l'equilibrio del microbioma in caso di squilibri.
In conclusione, i primi mille giorni di vita rappresentano una finestra di opportunità unica per modulare il microbioma e addestrare il sistema immunitario del bambino, con importanti ripercussioni sulla salute a lungo termine. Investire nella salute del microbioma durante l'infanzia è fondamentale per prevenire malattie e favorire una crescita sana e armoniosa del bambino.